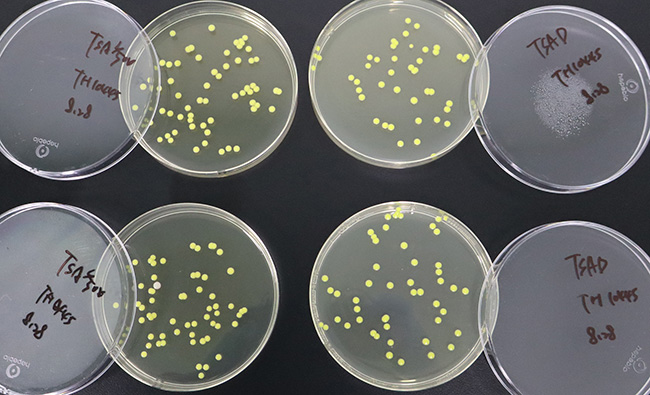
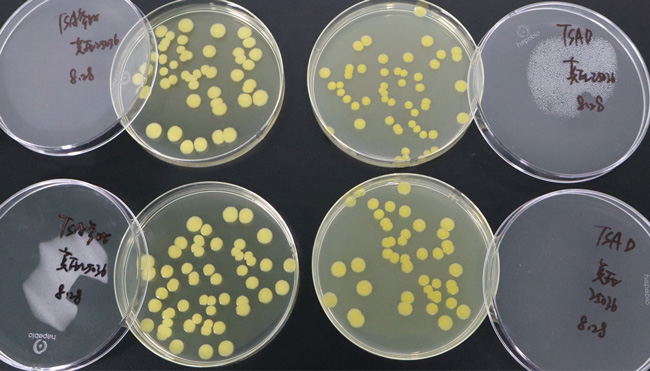
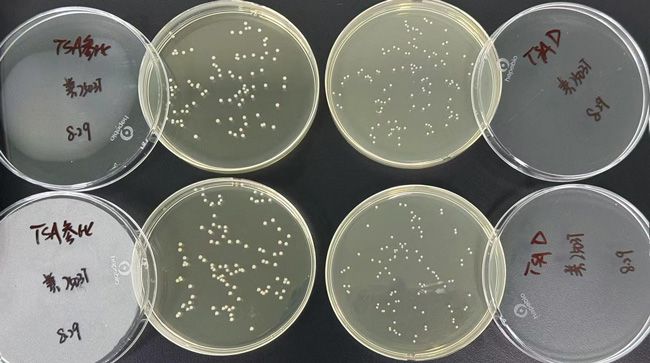

参比培养基:依据培养基配方特别制备,质量优良的培养基,用于培养基的质量控制,以保证食品微生物检验用培养基的质量。参比培养基需由具备相应检验能力,并取得通过国家认证认可资质检验机构出具的检测报告。海博生物参比培养基系列产品的配方及质量控制均符合GB4789.28-2024标准要求,并可出具CNAS报告,请放心使用。
用途:一种通用的营养培养基,用于各种微生物的培养。
包装方式:一次性无菌塑料平皿 9cm 辐照灭菌
成分(g/L)
胰蛋白胨
|
15.0
|
大豆胨
|
5.0
|
氯化钠
|
5.0
|
琼脂
|
15.0
|
pH值7.3±0.2
|
25℃
|
检验原理:
胰蛋白胨、大豆胨提供氮源、维生素和生长因子;氯化钠维持均衡的渗透压;琼脂是培养基的凝固剂。
不同细菌在胰蛋白胨大豆琼脂(TSA)上的生长特征:

|
|
|
|

|
|
金黄色葡萄球菌
有黄色色素
|
|
|
|
大肠埃希氏菌
无色透明大菌落
|
|
|
|
|
|

|
|
|
|

|
|
鼠伤寒沙门氏菌
无色大菌落
|
|
|
|
铜绿假单胞菌
有绿色色素
|
|
|
|
|
|

|
|
|
|

|
|
枯草芽孢杆菌
白色不规则菌落
|
|
|
|
白色念珠菌
白色菌落
|
|
|
|
|
|

|
|
黑曲霉
白色菌丝
|
|
|
藤黄微球菌
生长良好,黄色圆形菌落
|
|
|
莫氏克罗诺杆菌
生长良好,黄色菌落
|
|
|
粪肠球菌
生长良好,白色圆形菌落
|
胰蛋白胨大豆琼脂(TSA)平板(9cm)(参比培养基)微生物灵敏度试验:
按标签用法制备培养基,接种以下质控菌株,放置36℃需氧培养24±2小时。

标准依据: